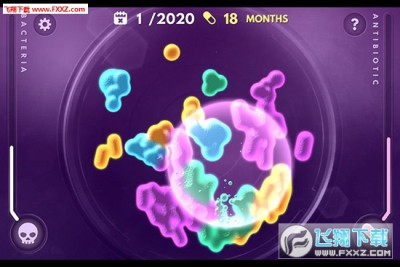

系统:Android 大小:19.6M
类型:休闲益智 更新:2016-07-08

《超级病毒手机版》是一款类似于瘟疫公司的手机游戏,游戏以病毒为主要的游戏题材,游戏中玩家扮演的医学专家要针对各种病毒来研究开发出各种抗生素,让人类可以长久的生存下去。喜欢的玩家赶紧下载体验吧!
《超级病毒 Superbugs》是一款关于细菌的休闲游戏。这款游戏客观地反映了我们现在的医疗模式,使用抗生素对抗细菌,刚开始我们能使用抗生素迅速的消灭细菌,但随着时间的流逝,细菌们有了抗体,抗生素便不再那么有效,而我们这时该如何才能生存的更久呢?
玩家在游戏中将会作为一名医学专家,对抗各种各样的超级病毒、突变细菌和抗生素。玩家需要在游戏中创造各种各样的抗生素,用来对抗耐药性越来越强的病毒。玩家在游戏中不仅仅需要创建新的抗生素,还需要对之前出现过的病毒进行管理,并通过对他的变异来提出改进方式。
1.在病原体的传播、感染的过程中,玩家需要不断修正其传染性和抵抗力,以便应对来自世界各国政府及科学家们的反击措施。
2.除此之外,游戏还增加了基因链系统、一键解药研发清零系统为玩家提供更爽的游戏体验。
游戏要求玩家将所选定的病原体散布到世界各地,从而制造一场超级病毒,最终让全人类死于该传染病。
